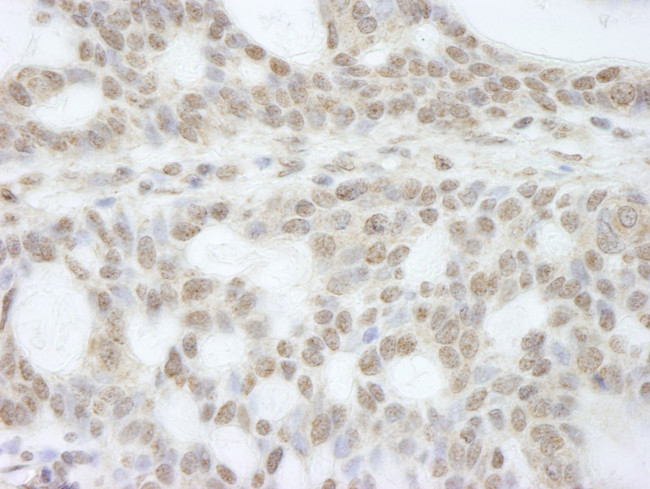
ATRX Antibody in Immunohistochemistry (Paraffin) (IHC (P))

Search
Bethyl Laboratories
ATRX Polyclonal Antibody
{{$productOrderCtrl.translations['antibody.pdp.commerceCard.promotion.promotions']}}
{{$productOrderCtrl.translations['antibody.pdp.commerceCard.promotion.viewpromo']}}
{{$productOrderCtrl.translations['antibody.pdp.commerceCard.promotion.promocode']}}: {{promo.promoCode}} {{promo.promoTitle}} {{promo.promoDescription}}. {{$productOrderCtrl.translations['antibody.pdp.commerceCard.promotion.learnmore']}}
产品信息
IHC-00236
种属反应
宿主/亚型
分类
类型
抗原
偶联物
形式
浓度
规格
纯化类型
保存液
内含物
保存条件
运输条件
产品详细信息
The recommended shelf life for this product is 1 year from date of receipt.
Based on 100% sequence identity, this antibody is predicted to react with Rabbit, Pig, Panda, Orangutan, Monkey, Gorilla, Chimpanzee, Northern white-cheeked gibbon and Little brown bat
靶标信息
ATRX encodes a protein that contains an ATPase/helicase domain, and thus it belongs to the SWI/SNF family of chromatin remodeling proteins. The mutations of this gene are associated with an X-linked mental retardation (XLMR) syndrome most often accompanied by alpha-thalassemia (ATRX) syndrome. These mutations have been shown to cause diverse changes in the pattern of DNA methylation, which may provide a link between chromatin remodeling, DNA methylation, and gene expression in developmental processes. This protein is found to undergo cell cycle-dependent phosphorylation, which regulates its nuclear matrix and chromatin association, and suggests its involvement in the gene regulation at interphase and chromosomal segregation in mitosis. Multiple alternatively spliced transcript variants encoding distinct isoforms have been reported.
仅用于科研。不用于诊断过程。未经明确授权不得转售。
篇参考文献 (0)
生物信息学
蛋白别名: ATP-dependent helicase ATRX; ATRX; helicase 2; RP5-875J14.1; Transcriptional regulator ATRX; unnamed protein product; X-linked helicase II; X-linked nuclear protein; XNP; Znf-HX
基因别名: ATRX; JMS; MRX52; RAD54; RAD54L; XH2; XNP; ZNF-HX
UniProt ID: (Human) P46100
Entrez Gene ID: (Human) 546